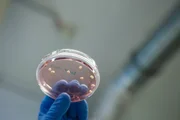

Registrierung zur E-Mail-Benachrichtigung
Anmeldung zur kostenlosen Serienstart-Benachrichtigung für
- E-Mail-Adresse
- Für eine vollständige und rechtzeitige Benachrichtigung übernehmen wir keine Garantie.
- Fragen & Antworten
P.M. Wissen
A, 2018–2024

136 Fans- Serienwertung0 35545noch keine Wertungeigene: –
Bildergalerie zu "P.M. Wissen"
Folge 33Mit der Zeitlupe lässt sich erforschen, was dem menschlichen Auge eigentlich verborgen bleibt.Bild: © Servus TV / Bilderfest GmbH
Folge 1Sunrise, Space, Outer, Globe, World, Earth, Sun, RiseBild: © CC0 Creative Commons
Folge 85Statussymbol – oder kriegerische Waffe? Ein etwa 3000 Jahre altes bronzezeitliches Schwert. Es besteht zu 88 Prozent aus Kupfer und zu zwölf Prozent aus Zinn.Bild: © ServusTV Deutschland
Gernot GrömerBild: © Servus TV / Neumayr / Leo
Folge 106Bild: © ServusTV / Bilderfest
Folge 106Bild: © ServusTV / Bilderfest
Folge 61SchweinBild: © Getty Images / GK Hart / Vikki Hart
Folge 33Schon seit über 100 Jahren können Zuschauer Bilder in Zeitlupe bestaunen – zu verdanken haben sie das einem Österreicher.Bild: © Servus TV / Bilderfest GmbH
Folge 34Dass Pflanzen zur Sonne hin wachsen, ist bekannt. Woher aber wissen Wurzeln, wohin sie wachsen müssen? Um das zu untersuchen, wird am Institute of Science and Technology in Klosterneuburg am Ackerschmalwand geforscht.Bild: © ServusTV / Bilderfest
Etwa 5 Millimeter große, weiße Kügelchen schwimmen in der roten Nährlösung: solche Gehirn Organoide könnten der Schlüssel sein zum Verständnis zahlreicher neurologischer Erkrankungen wie Epilepsie, Schizophrenie oder Mikrozephalie.Bild: © ServusTV / Bilderfest
Folge 97Wie falsch sind unsere Erinnerungen?Bild: © ServusTV / Bilderfest
Folge 106Bild: © ServusTV / Bilderfest
Folge 1Earth, Globe, Moon, World, PlanetBild: © CC0 Creative Commons
Folge 68Die Radioteleskope des NOEMA-Observatoriums stehen auf einem Plateau in über 2500 Metern Höhe in den französischen Alpen.Bild: © ServusTV / Bilderfest
Folge 118Wechseln Chamäleons ihre Farbe zur Tarnung – oder kommunizieren sie auf diese Weise miteinander?Bild: © ServusTV / Bilderfest
VampirBild: © Getty Images/Ivan Bliznetsov/Model and Property Released (MR&PR)/D-Keine
Folge 86Rundrücken, geschwollene Gelenke, gereizte Augen – werden alle Büroangestellten in 20 Jahren aussehen wie Emma, diese lebensgroße Figur?Bild: © Fellowes
Folge 86Rundrücken, geschwollene Gelenke, gereizte Augen – werden alle Büroangestellten in 20 Jahren aussehen wie Emma, diese lebensgroße Figur?Bild: © Fellowes
Folge 86Rundrücken, geschwollene Gelenke, gereizte Augen – werden alle Büroangestellten in 20 Jahren aussehen wie Emma, diese lebensgroße Figur?Bild: © Fellowes
Folge 129ADLER-1 ist ein sogenannter Cubesat, also ein Satellit aus kleinen Würfeln von je zehn Zentime-ter Seitenlänge - insgesamt misst er 30x10x10 Zentimeter. Aus dem Grundgerüst lassen sich Solarzellen (unten/oben) und die beiden Flügel (rechts) mit je zwölf Sensorflächen ausklappen.Bild: © ServusTV / Bilderfest
Folge 67Bild: © Servus TV / Neumayr / Leo
Folge 86Rundrücken, geschwollene Gelenke, gereizte Augen – werden alle Büroangestellten in 20 Jahren aussehen wie Emma, diese lebensgroße Figur?Bild: © Fellowes
Folge 30In rund 80 Tunneln in Österreich muss in diesem Jahr die Lüftung an neue EU Richtlinien angepasst werden – zur Verstärkung der Sicherheit.Bild: © ServusTV / Bilderfest
Folge 38Toilette die ohne Wasserspülung funktioniertBild: © Servus TV
Folge 129ADLER-1 ist ein sogenannter Cubesat, also ein Satellit aus kleinen Würfeln von je zehn Zentime-ter Seitenlänge - insgesamt misst er 30x10x10 Zentimeter. Aus dem Grundgerüst lassen sich Solarzellen (unten/oben) und die beiden Flügel (rechts) mit je zwölf Sensorflächen ausklappen.Bild: © ServusTV / Bilderfest
Folge 102Wie kann man mit Wasser Stahl schneiden?Bild: © ServusTV / Bilderfest
Spezial: Unser Universum - Von der Entstehung des Sonnensystems bis zu den menschlichen Spuren im AllBild: © ServusTV / Bilderfest
Folge 23Dieses 1500-Tonnen-Schiff soll seitlich ins Wasser gelassen werden. Ob das gut geht?Bild: © ServusTV / Bilderfest
Folge 106Auch bei den Dreharbeiten wechseln sich Sonne und Wolken, Regen und Schnee ab.Bild: © ServusTV / Bilderfest
Folge 59Welche Corona-Mythen sind Fake News?Bild: © Getty Images/Not Released (NR)/malerapaso/malerapaso
Folge 124Ein neuartiger Verband soll Brandwunden künftig besser überwachen und behandeln lassen.Bild: © ServusTV / Bilderfest
Folge 24Damit die Messungen nicht von magnetischen Störeinflüssen beeinträchtigt werden, befindet sich das Conrad Observatorium der Zentralanstalt für Meteorologie und Geodynamik (ZAMG) tief unten in einem Berg.Bild: © ServusTV / Bilderfest
Folge 97Wie falsch sind unsere Erinnerungen?Bild: © ServusTV / Bilderfest
Folge 97Wie falsch sind unsere Erinnerungen?Bild: © ServusTV / Bilderfest
Folge 105Bild: © ServusTV / Bilderfest
Etwa 5 Millimeter große, weiße Kügelchen schwimmen in der roten Nährlösung: solche Gehirn Organoide könnten der Schlüssel sein zum Verständnis zahlreicher neurologischer Erkrankungen wie Epilepsie, Schizophrenie oder Mikrozephalie.Bild: © ServusTV / Bilderfest
Meistgelesene TV-News
- Quoten: Raab-Schöneberger-Show trotz Verlusten erneut erfolgreich, "The Voice Kids" bricht ein
- "Wilsberg": Zwei neue 90-Minüter der ZDF-Erfolgskrimireihe werden gedreht
- "Dutton Ranch": Dann startet das "Yellowstone"-Spin-off mit Kelly Reilly und Cole Hauser
- "Stranger Things"-Star übernimmt Hauptrolle in Netflix-Bestselleradaption
- Die "Totenfrau" kehrt zurück: Deutsche Free-TV-Premiere für Staffel 2
Neueste Meldungen
Die Vorschau - Unser neuer Podcast

Mario präsentiert die besten Serienstarts der kommenden Woche.
Newsletter
Abonniere unseren kostenlosen wöchentlichen Newsletter mit allen TV- und Streamingstarts der Woche.